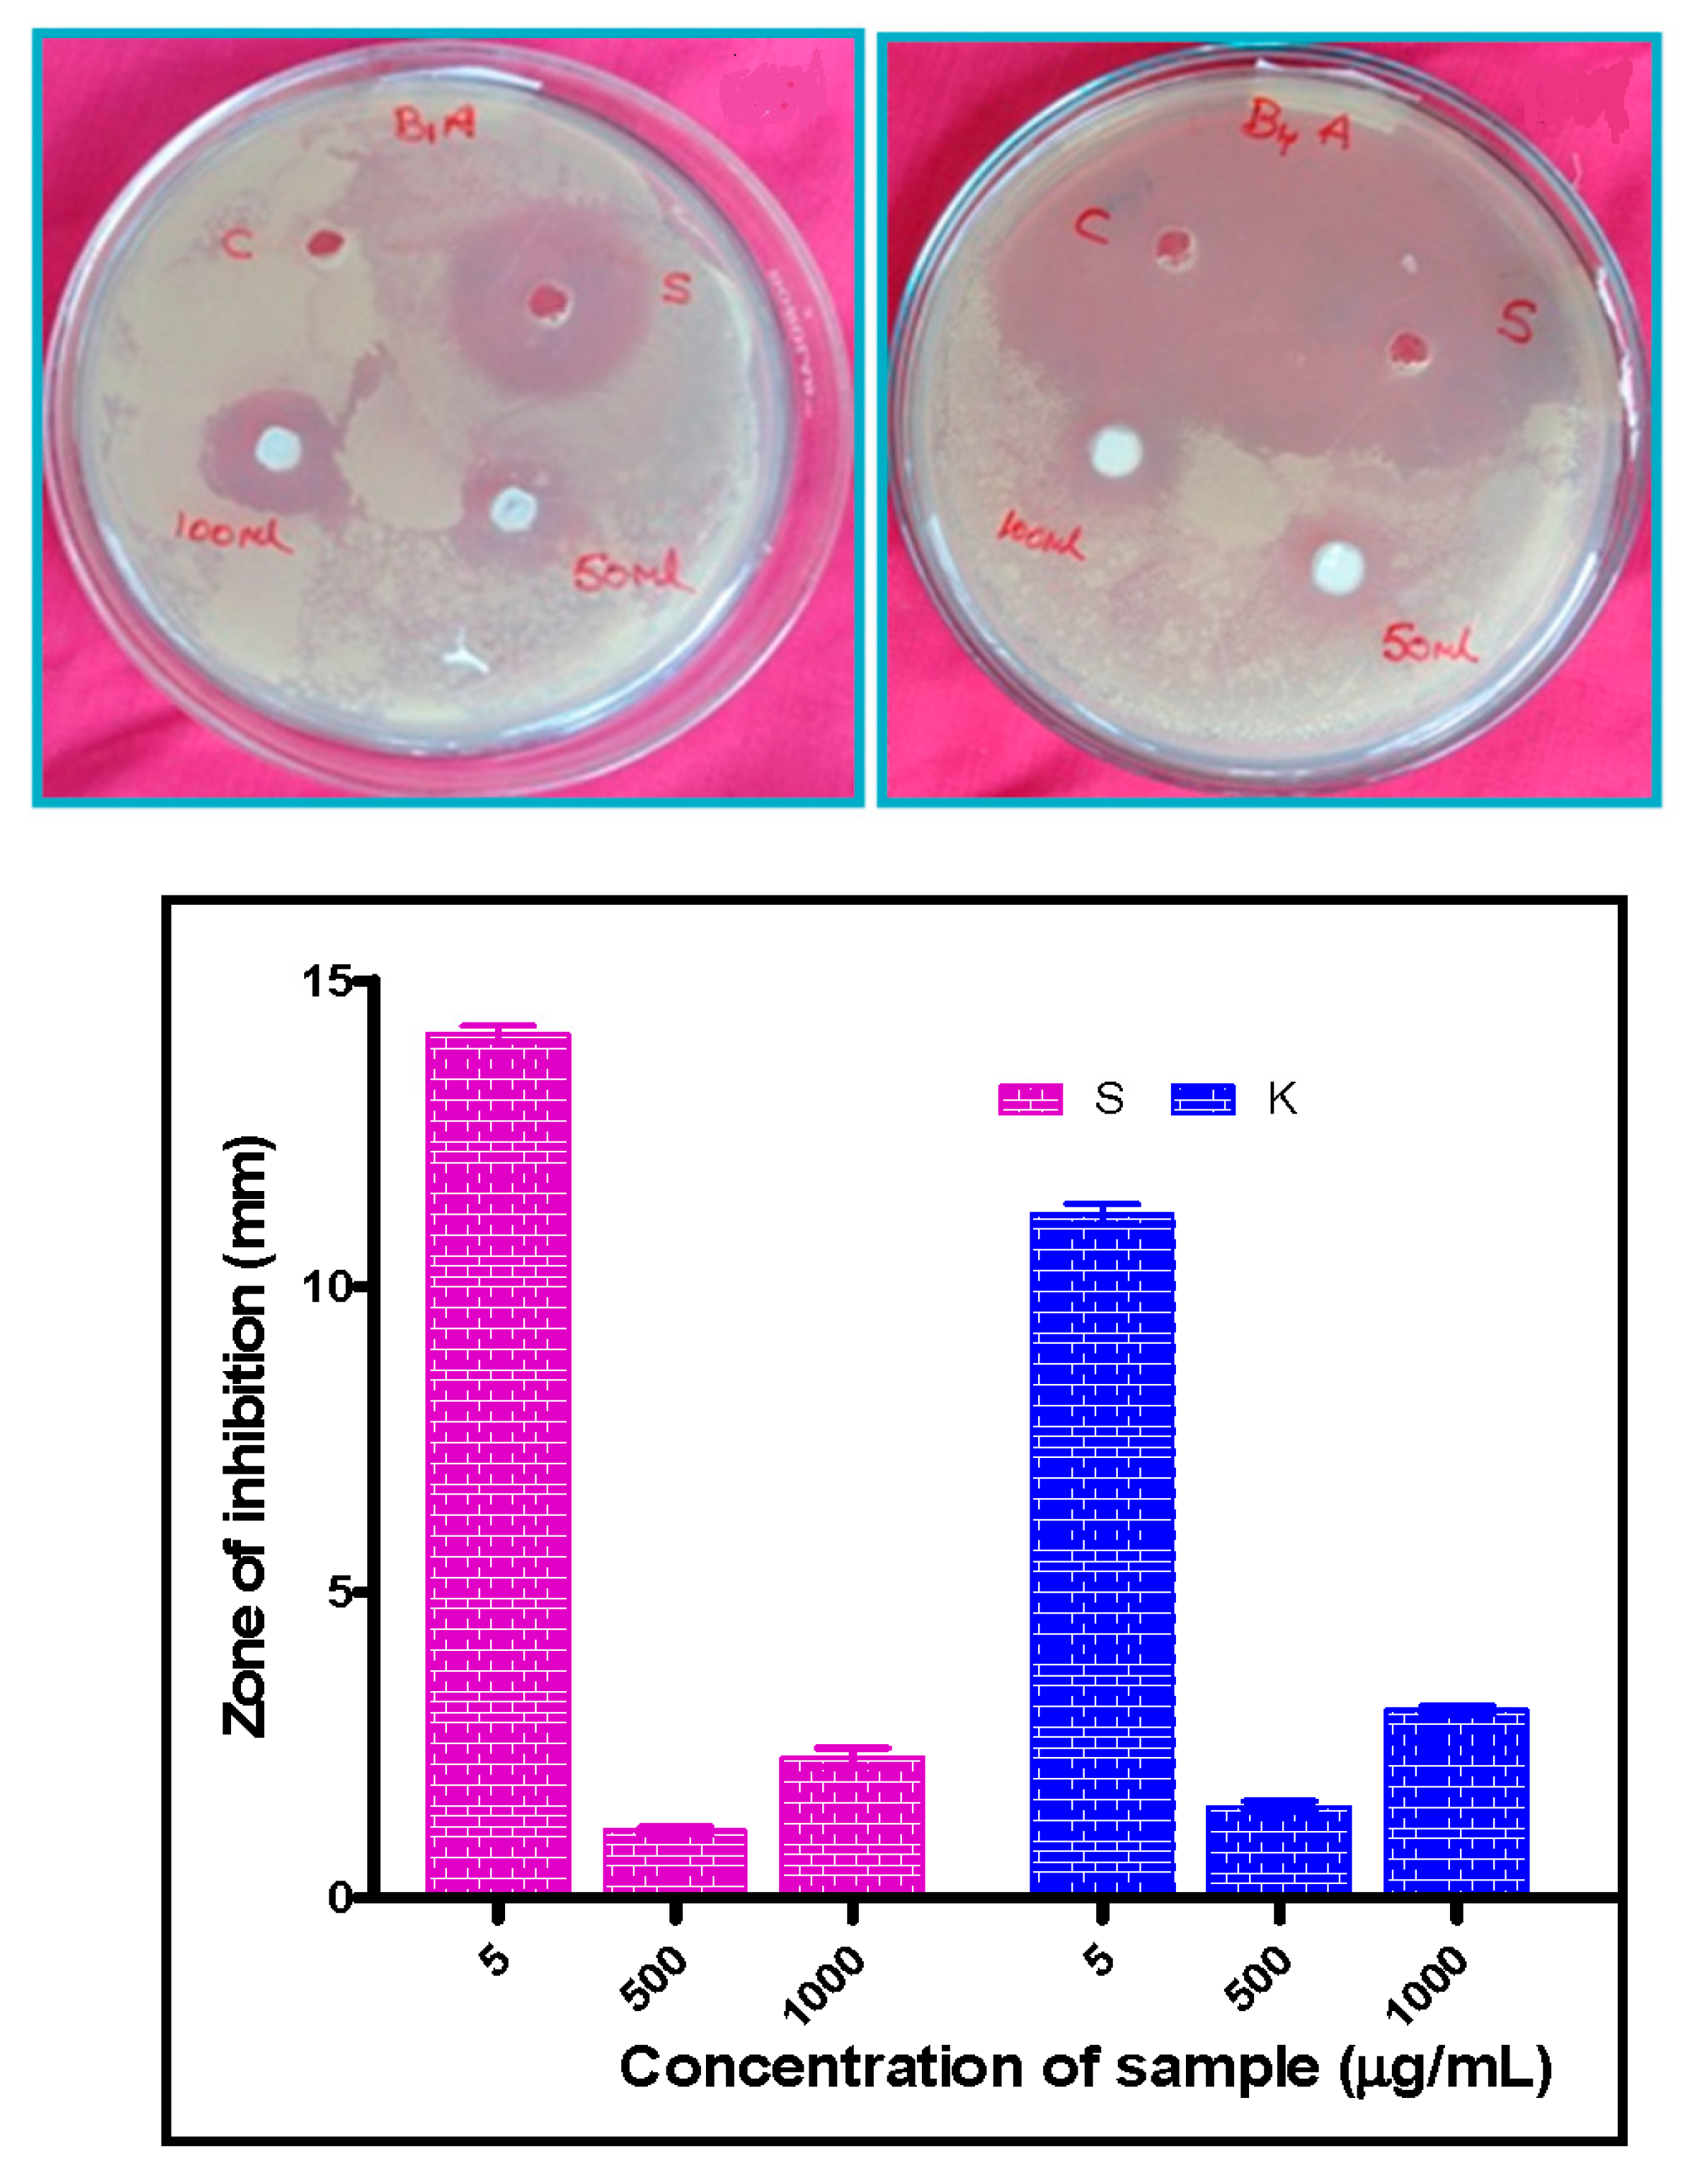
Crystals 10 00817 g012 Crystals 10 00817 g012

Effect of CeO2-ZnO Nanocomposite for Photocatalytic and Antibacterial Activities
Abstract
1. Introduction
2. Experimental
2.1. Materials
2.2. Extraction of Fuel from Fruits of Acacia Nilotica
2.3. Synthesis of CeO2-ZnO Nanocomposite
2.4. Characterization
2.5. Photocatalytic Experiment
3. Results and Discussion
3.1. XRD Analysis
3.2. FTIR Analysis
3.3. Raman Spectroscopy
3.4. Optical Properties
3.5. Photoluminescence Properties
3.6. SEM Analysis
3.7. TEM Analysis
3.8. Surface Area Analysis from BET
3.9. Photocatalytic Properties
3.10. Antibacterial Properties
4. Conclusions
Author Contributions
Funding
Acknowledgments
Conflicts of Interest
References
- Zi-Qiang, X.; Hong, D.; Hang, C. Al-doping effects on structure, electrical and optical properties of c-axis orientated ZnO: Al thin films. Mater. Sci. Semicond. Process. 2006, 9, 132–135. [Google Scholar] [CrossRef]
- Liu, Y.; Kanhere, P.D.; Wong, C.L.; Tian, Y.; Feng, Y.; Boey, F.; Wu, T.; Chen, H.; White, T.J.; Chen, Z.; et al. Hydrazine-hydrothermal method to synthesize three-dimensional chalcogenide framework for photocatalytic hydrogen generation. J. Solid State Chem. 2010, 183, 2644–2649. [Google Scholar] [CrossRef]
- Neri, G.; Bonavita, A. Ethanol sensors based on Pt-doped tin oxide nanopowders synthesized by gel combustion. Sens. Actuators B Chem. 2006, 117, 196–204. [Google Scholar] [CrossRef]
- Liang, Y.; Wicker, S.; Wang, X.; Erichsen, E.S.; Fu, F. Organozinc precursor-derived crystalline ZnO nanoparticles: Synthesis, characterization and their spectroscopic properties. Nanomaterials 2018, 8, 22–30. [Google Scholar]
- Nie, L.; Zhang, Q. Recent progress in crystalline metal chalcogenides as efficient photocatalysts for organic pollutant degradation. Inorg. Chem. Front. 2017, 4, 1953–1962. [Google Scholar] [CrossRef]
- Ewen, R.J.; Ratcliffe, N.M. Highly sensitive mixed oxide sensors for the detection of ethanol. Sens. Actuators B Chem. 2002, 87, 207–210. [Google Scholar]
- Yamashita, H.; Nose, H. TiO2 photocatalyst loaded on hydrophobic Si3N4support for efficient degradation of organics diluted in water. Appl. Catal. A Gen. 2008, 350, 164–168. [Google Scholar] [CrossRef]
- Nagaraju, G.; Shivaraju, G.C. Photocatalytic activity of ZnO nanoparticles: Synthesis via solution combustion method. Mater. Today Proc. 2017, 4, 11700–11705. [Google Scholar] [CrossRef]
- Yadav, L.R.; Lingaraju, K.; Prasad, B.D.; Kavitha, C.; Banuprakash, G.; Nagaraju, G. Synthesis of CeO2 nanoparticles: Photocatalytic and antibacterial activities. Eur. Phys. J. Plus. 2017, 132, 1–10. [Google Scholar]
- Jung, S.M.; Lim, H.Y. Advanced photocatalytic activity using TiO2/ceramic fiber-based honeycomb. Stud. Surf. Sci. Catal. 2010, 175, 441–444. [Google Scholar]
- Xiong, L. Fast and simplified synthesis of cuprous oxide nanoparticles: Annealing studies and photocatalytic activity. RSC Adv. 2014, 4, 62115–62122. [Google Scholar] [CrossRef]
- Hajipour, M.J.; Fromm, K.M. Antibacterial properties of nanoparticles. Trends Biotechnol. 2012, 30, 499–511. [Google Scholar] [CrossRef] [PubMed]
- Yadav, L.R.; Nagaraju, G. Fruit juice extract mediated synthesis of CeO2 nanoparticles for antibacterial and photocatalytic activities. Eur. Phys. J. Plus. 2016, 131, 54–61. [Google Scholar]
- Rajesh, S.; Reddy, Y.L.S. Structural, optical, thermal and photocatalytic properties of ZnO nanoparticles of betel leave by using green synthesis method. J. Nanostruct. 2016, 6, 250–255. [Google Scholar]
- Yadav, L.R.; Nagaraju, G. Synergistic effect of MgO nanoparticles for electrochemical sensing, photocatalytic-dye degradation and antibacterial activity. Mater. Res. Express 2017, 4, 25–28. [Google Scholar]
- Ravishankar, T.N.; Nagaraju, G. Synthesis and characterization of CeO2 nanoparticles via solution combustion method for photocatalytic and antibacterial activity studies. Chemistry 2015, 4, 146–154. [Google Scholar] [CrossRef] [PubMed]
- Mishra, P.K.; Vaidya, B. Zinc oxide nanoparticles: A promising nanomaterial for biomedical applications. Drug Discov. Today 2017, 22, 1825–1834. [Google Scholar] [CrossRef]
- Davis, K.; White, J. Band gap engineered zinc oxide nanostructures via a sol–gel synthesis of solvent driven shape-controlled crystal growth. RSC Adv. 2019, 9, 14638–14648. [Google Scholar] [CrossRef]
- Wang, Z.L. Zinc oxide nanostructures: Growth, properties and applications. J. Phys. Condens. Matter 2004, 16, R829–R858. [Google Scholar] [CrossRef]
- Zhong, Q.; Matijevic, E. Preparation of uniform zinc oxide colloids by controlled double-jet precipitation. J. Mater. Chem. 1996, 6, 443–447. [Google Scholar] [CrossRef]
- Wang, L.; Muhammed, M. Synthesis of zinc oxide nanoparticles with controlled morphology. J. Mater. Chem. 1999, 9, 2871–2878. [Google Scholar] [CrossRef]
- Bahnemann, B.W.; Hoffmann, M.R. Preparation and characterization of quantum size zinc oxide: A detailed spectroscopic study. J. Phys. Chem. 1987, 91, 3789–3798. [Google Scholar] [CrossRef]
- Zhang, H.; Que, D. Synthesis of flower-like ZnO nanostructures by an organic-free hydrothermal process. Nanotechnology 2004, 15, 622–626. [Google Scholar] [CrossRef]
- Zhang, J.; Yan, C. Control of ZnO morphology via a simple solution route. Chem. Mater. 2002, 14, 4172–4177. [Google Scholar] [CrossRef]
- Li, W.J.; Shi, E.W. Hydrothermal preparation of nanometer ZnO powders. J. Mater. Sci. Lett. 2001, 20, 1381–1383. [Google Scholar] [CrossRef]
- Chen, W.; Zhang, L. Sonochemical processes and formation of gold nanoparticles within pores of mesoporous silica. J. Colloid Interface Sci. 2001, 238, 291–295. [Google Scholar] [CrossRef]
- Pavithra, N.S.; Lingaraju, K.; Raghu, G.K.; Nagaraju, G. Citrus maxima (Pomelo) juice mediated eco- friendly synthesis of ZnO nanoparticles: Applications to photocatalytic, electrochemical sensor and antibacterial activities. Spectrochim. Acta Part. A: Mol. Biomol. Spectrosc. 2017, 185, 11–19. [Google Scholar] [CrossRef]
- Ramasami, A.K.; Nagabhushana, H.; Nagaraju, G. Tapioca starch: An efficient fuel in the gel-combustion synthesis of photocatalytically and anti-microbially active ZnO nanoparticles. Mater. Charact. 2015, 99, 266–276. [Google Scholar] [CrossRef]
- Kumar, C.R.; Betageri, V.S.; Nagaraju, G.; Pujar, G.H.; Onkarappa, H.S.; Latha, M.S. Synthesis of core/Shell ZnO/Ag nanoparticles using calotropis gigantea and their applications in photocatalytic and antibacterial Studies. J. Inorg. Organomet. Polym. Mater. 2020, in press. [Google Scholar] [CrossRef]
- Manjunath, K.; RajaNaika, H.; Dupont, J.; Nagaraju, G. Facile combustion synthesis of ZnO nanoparticles using Cajanus cajan (L.) and its multidisciplinary applications. Mater. Res. Bull. 2014, 57, 325–334. [Google Scholar] [CrossRef]
- Priya, G.S.; Kanneganti, A. Biosynthesis of cerium oxide nanoparticles using aloe barbadensis miller gel. Int. J. Sci Res. Publ. 2014, 4, 199–224. [Google Scholar]
- Malleshappa, J.; Vidya, Y.S. Leucasaspera mediated multifunctional CeO2 nanoparticles: Structural, photoluminescent, photocatalytic and antibacterial properties. Spectrochim. Acta Part. A Mol. Biomol. Spectrosc. 2015, 149, 452–462. [Google Scholar] [CrossRef]
- Zak, A.K.; Ren, Z.F. Sonochemical synthesis of hierarchical ZnO nanostructures. Ultrason. Sonochem. 2013, 20, 395–400. [Google Scholar]
- Taufik, A. Different heat treatment of CeO2 nanoparticle composited with ZnO to enhance photocatalytic performance. IOP Conf. Series Mat. Sci. Eng. 2017, 188, 012–038. [Google Scholar]
- Lin, F.; Alxneit, I.; Wokaun, A. Structural and chemical changes of Zn-doped CeO2 nanocrystals upon annealing at ultra-high temperatures. Cryst. Eng. Commun. 2015, 17, 1646–1653. [Google Scholar] [CrossRef][Green Version]
- Faisal, M.; Abdullah, M.M. Smart chemical sensor and active photo-catalyst for environmental pollutants. Chem. Eng. J. 2011, 173, 178–184. [Google Scholar] [CrossRef]
- Ramasamy, V.; Vijayalakshmi, G. Effect of Zn doping on structural, optical and thermal properties of CeO2 nanoparticles. Superlattices Microstruct. 2015, 85, 510–521. [Google Scholar] [CrossRef]
- Tju, H.; Shabrany, H. Degradation of methylene blue (MB) using ZnO/CeO2/nanographene platelets (NGP) photocatalyst: Effect of various concentration of NGP. AIP Conf. Proce. 2017, 1862, 030037-5. [Google Scholar]
- Prabhu, S.; Viswanathan, T.; Jothivenkatachalam, K.; Jeganathan, K. Visible Light Photocatalytic Activity of CeO2-ZnO-TiO2 Composites for the Degradation of Rhodamine, B. Indian J. Mat. Sci. 2014, 536123, 1–10. [Google Scholar] [CrossRef]
- Deepa, K.; Venkatesh, T.V. Synthesis of CeO2 doped ZnO nanoparticles and their application in Zn-composite coating on mild steel. Arab. J. Chem. 2020, 13, 2309–2317. [Google Scholar]
- Faisal, M.; Abdulla, M.M. Role of ZnO-CeO2 Nanostructures as a Photo-catalyst and Cheema-sensor. J. Mater. Sci. Technol. 2011, 27, 594–600. [Google Scholar] [CrossRef]
- Sahar, M.; Ghada, M.M.; Nady, A.F.; Gehan, A.F. Effect of nanosize CeO2 or ZnO loading on adsorption and catalytic properties of activated carbon. Adsorp. Sci. Technol. 2017, 35, 774–788. [Google Scholar]
- Anushree; Kumar, S.; Sharma, C. Synthesis, characterization and catalytic performance of ZnO–CeO2 nanoparticles in wet oxidation of wastewater containing chlorinated compounds. Appl. Nanosci. 2017, 7, 567–575. [Google Scholar] [CrossRef]
- Lan, S.; Sheng, X. Modification of antibacterial ZnO nanorods with CeO2 nanoparticles: Role of CeO2 in impacting morphology and antibacterial activity. Colloid Interf. Sci. Commun. 2018, 26, 32–38. [Google Scholar] [CrossRef]
- Qiao, X.Q.; Zhang, Z.W.; Li, Q.H.; Hou, D.; Zhang, Q.; Zhang, J.; Li, D.S.; Feng, P.; Bu, X. In situ synthesis of n–n Bi2MoO6 &Bi2S3 heterojunctions for highly efficient photocatalytic removal of Cr 6. J. Mater. Chem. A 2018, 6, 22580–22589. [Google Scholar]
- Zhu, L.; Li, H.; Xia, P.; Liu, Z.; Xiong, D. Hierarchical ZnO decorated with CeO2 nanoparticles as the direct Z-Scheme heterojunction for enhanced photocatalytic activity. ACS Appl. Mater. Interfaces 2018, 10, 39679–39687. [Google Scholar] [CrossRef]
- Saravanan, R.; Mohammad, M.K.; Khan, F.G.; Jiaqian, Q.; Vinod, K.G.; Stephen, A. Ce3+ - ion-induced visible-light photocatalytic degradation and electrochemical activity of ZnO/CeO2 nanocomposite. Sci. Rep. 2016, 6, 31641–31642. [Google Scholar]

| Sl. No | Treatment | K. Aerogenes (K) (Mean ± SE, mm) | S. Aureus (S) (Mean ± SE, mm) |
|---|---|---|---|
| I | Standard (5 µg/50 µL) | 11.17 ± 0.17 | 14.13 ± 0.13 |
| II | CeO2-ZnO (500 µg/50 µL) | 1.49 ± 0.09 | 1.10 ± 0.06 |
| III | CeO2-ZnO (1000 µg/100 µL) | 3.07 ± 0.07 | 2.30 ± 0.15 |
© 2020 by the authors. Licensee MDPI, Basel, Switzerland. This article is an open access article distributed under the terms and conditions of the Creative Commons Attribution (CC BY) license (http://creativecommons.org/licenses/by/4.0/).
Share and Cite
Syed, A.; Yadav, L.S.R.; Bahkali, A.H.; Elgorban, A.M.; Abdul Hakeem, D.; Ganganagappa, N. Effect of CeO2-ZnO Nanocomposite for Photocatalytic and Antibacterial Activities. Crystals 2020, 10, 817. https://doi.org/10.3390/cryst10090817
Syed A, Yadav LSR, Bahkali AH, Elgorban AM, Abdul Hakeem D, Ganganagappa N. Effect of CeO2-ZnO Nanocomposite for Photocatalytic and Antibacterial Activities. Crystals. 2020; 10(9):817. https://doi.org/10.3390/cryst10090817
Chicago/Turabian StyleSyed, Asad, Lakshmi Sagar Reddy Yadav, Ali H. Bahkali, Abdallah M. Elgorban, Deshmukh Abdul Hakeem, and Nagaraju Ganganagappa. 2020. "Effect of CeO2-ZnO Nanocomposite for Photocatalytic and Antibacterial Activities" Crystals 10, no. 9: 817. https://doi.org/10.3390/cryst10090817
APA StyleSyed, A., Yadav, L. S. R., Bahkali, A. H., Elgorban, A. M., Abdul Hakeem, D., & Ganganagappa, N. (2020). Effect of CeO2-ZnO Nanocomposite for Photocatalytic and Antibacterial Activities. Crystals, 10(9), 817. https://doi.org/10.3390/cryst10090817

